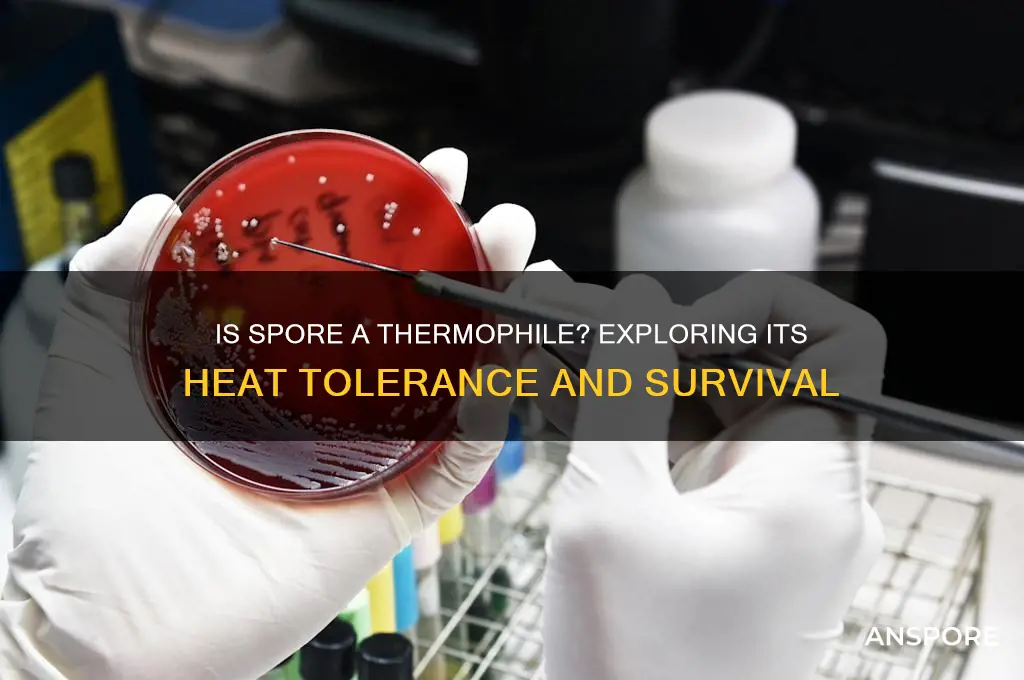
is spore a theromophile

The question of whether *Spore* is a thermophile is rooted in understanding both the term thermophile and the nature of *Spore*. Thermophiles are organisms that thrive in high-temperature environments, typically above 45°C, and are commonly found in extreme habitats like hot springs or hydrothermal vents. *Spore*, on the other hand, is a life simulation video game developed by Maxis and published by Electronic Arts, which allows players to guide the evolution of a species from microscopic organisms to interstellar explorers. Since *Spore* is a digital creation and not a biological entity, it cannot be classified as a thermophile. However, the game does explore themes of adaptation and survival in diverse environments, including extreme conditions, which might spark curiosity about how life forms could evolve in such settings.
What You'll Learn
- Spore's Optimal Growth Temperature: Examines if spores thrive in high-temperature environments typical for thermophiles
- Thermophilic Spore Species: Identifies specific spore-forming organisms classified as thermophiles
- Spore Heat Resistance: Explores spores' ability to survive extreme heat, a thermophile trait
- Spore vs. Thermophile Definition: Compares spore characteristics to the scientific definition of thermophiles
- Environmental Spore Habitats: Investigates if spore habitats align with thermophilic temperature ranges

Spore's Optimal Growth Temperature: Examines if spores thrive in high-temperature environments typical for thermophiles
Spores, the dormant, resilient structures produced by certain bacteria, fungi, and plants, are renowned for their ability to withstand extreme conditions. However, their optimal growth temperature remains a critical factor in determining their viability and proliferation. While spores are often associated with survival in harsh environments, the question arises: do they thrive in the high-temperature environments typical for thermophiles, organisms that flourish at temperatures between 50°C and 80°C? To address this, we must examine the physiological adaptations of spores and the conditions under which they transition from dormancy to active growth.
From an analytical perspective, spores exhibit a unique dual nature. In their dormant state, they can endure temperatures far exceeding those tolerated by their vegetative counterparts, often surviving temperatures above 100°C for extended periods. This heat resistance is attributed to their robust cell wall composition, low water content, and DNA-protecting proteins. However, germination and subsequent growth require a different set of conditions. For instance, *Bacillus subtilis* spores, a well-studged example, germinate optimally at temperatures around 37°C to 50°C, far below the thermophilic range. This suggests that while spores can survive extreme heat, their transition to active growth is not necessarily optimized for high-temperature environments.
To explore this further, consider the instructive approach of laboratory experiments. Researchers often expose spores to controlled temperature gradients to observe germination rates. A study on *Geobacillus stearothermophilus*, a thermophilic bacterium, revealed that its spores germinate most efficiently at 55°C to 60°C. However, this is an exception rather than the rule. Most spore-forming organisms, such as *Clostridium botulinum*, exhibit optimal germination at temperatures below 40°C. Practical tips for researchers include pre-treating spores with specific nutrients (e.g., L-valine or inosine) to enhance germination efficiency, but even these measures do not shift optimal growth into the thermophilic range for non-thermophilic species.
A comparative analysis highlights the distinction between thermophilic organisms and spore-formers. Thermophiles, like *Thermus aquaticus*, possess enzymes and cellular machinery optimized for high temperatures, allowing both their vegetative and spore forms to function efficiently in hot environments. In contrast, mesophilic spore-formers, such as *Bacillus cereus*, prioritize survival over growth in extreme conditions. Their spores act as a survival mechanism, enabling them to persist until conditions become favorable for growth, typically at moderate temperatures. This comparison underscores that while spores can endure high temperatures, they are not inherently thermophiles.
In conclusion, spores do not thrive in high-temperature environments typical for thermophiles. Their optimal growth temperatures generally align with mesophilic ranges, reflecting their role as survival structures rather than active growth forms in extreme heat. While exceptions like *Geobacillus* exist, the majority of spore-forming organisms are adapted to germinate and grow under milder conditions. Understanding this distinction is crucial for applications in biotechnology, food safety, and environmental microbiology, where spore behavior under various temperatures directly impacts outcomes.
Boost Your Spore PC T Level: Effective Strategies for Rapid Growth
You may want to see also

Thermophilic Spore Species: Identifies specific spore-forming organisms classified as thermophiles
Spore-forming organisms are renowned for their resilience, capable of surviving extreme conditions by entering a dormant state. Among these, thermophilic spore species stand out for their ability to thrive in high-temperature environments, often exceeding 50°C. These microorganisms are not merely survivors; they are active contributors to ecosystems and industries, from geothermal springs to food fermentation. Identifying specific thermophilic spore-forming organisms is crucial for understanding their ecological roles and harnessing their potential in biotechnology.
One prominent example is *Geobacillus stearothermophilus*, a bacterium widely used as a bioindicator in sterilization processes. This species forms spores that can withstand temperatures up to 80°C, making it a gold standard for validating autoclave efficiency. Its spores are so heat-resistant that they are often employed in commercial spore suspensions to test sterilization equipment. For practical applications, a common dosage of 10^6 spores per milliliter is used in these tests, ensuring reliable results. This organism’s thermophilic nature is not just a survival mechanism but a trait that makes it invaluable in industrial settings.
In contrast, *Thermus aquaticus* is another thermophilic spore-former, though less known for spore formation and more celebrated for its enzyme, Taq polymerase, essential in PCR technology. While its spores are less studied, its ability to grow optimally at 70°C highlights the diversity within thermophilic spore species. This bacterium thrives in hot springs, demonstrating how such organisms adapt to extreme environments. For researchers, isolating *T. aquaticus* from natural habitats requires careful temperature control during cultivation, typically between 65°C and 75°C, to mimic its native conditions.
A lesser-known but equally fascinating thermophilic spore-former is *Anoxybacillus pushchinensis*, found in hot springs and soil. This bacterium can grow at temperatures up to 65°C and forms spores that retain viability under prolonged heat exposure. Its spores are of interest in bioremediation, as they can degrade organic pollutants in high-temperature environments. For field applications, inoculating contaminated sites with *A. pushchinensis* spores at a concentration of 10^8 spores per gram of soil has shown promising results in breaking down hydrocarbons.
Understanding these specific thermophilic spore species not only expands our knowledge of microbial diversity but also opens avenues for their practical use. From industrial sterilization to biotechnology and environmental cleanup, these organisms offer solutions to challenges in high-temperature settings. By identifying and studying them, we unlock their potential to transform industries and contribute to scientific advancements. Each species, with its unique adaptations, serves as a testament to the remarkable capabilities of life under extreme conditions.
Painting Over Mold Spores: Risks, Remedies, and Effective Solutions
You may want to see also

Spore Heat Resistance: Explores spores' ability to survive extreme heat, a thermophile trait
Spores, the dormant, resilient forms of certain bacteria, fungi, and plants, exhibit a remarkable ability to withstand extreme heat. This heat resistance is a defining trait of thermophiles, organisms thriving in high-temperature environments. While not all spore-forming organisms are thermophiles, the heat resistance of spores shares striking similarities with thermophilic adaptations.
Understanding this connection is crucial for fields like food safety, where spore-forming bacteria like *Clostridium botulinum* pose significant risks, and biotechnology, where thermostable enzymes derived from spores are valuable tools.
The heat resistance of spores stems from their unique structure. A thick, multilayered coat composed of proteins and peptidoglycan acts as a protective shield, preventing heat-induced damage to the spore's genetic material and cellular components. Additionally, spores contain high levels of calcium dipicolinate, a molecule believed to stabilize the spore's internal structure and protect DNA from denaturation at high temperatures. This combination of structural and chemical defenses allows spores to survive temperatures exceeding 100°C, far beyond the tolerance of most life forms.
For instance, *Bacillus subtilis* spores can withstand pasteurization temperatures (72°C for 15 seconds), highlighting the challenge of eliminating them from food products.
Comparing spore heat resistance to thermophilic adaptations reveals intriguing parallels. Thermophiles possess specialized proteins and membrane structures that remain stable at high temperatures. Similarly, spore proteins are often highly stable, exhibiting resistance to denaturation. Both spores and thermophiles may utilize unique metabolic pathways and DNA repair mechanisms to cope with heat stress. However, a key distinction lies in their active versus dormant states. Thermophiles actively metabolize and reproduce in hot environments, while spores remain metabolically inactive, relying on their protective structures for survival.
This comparison underscores the convergent evolution of heat resistance strategies in diverse organisms.
Harnessing spore heat resistance has practical applications. In food preservation, understanding spore survival mechanisms guides the development of more effective sterilization techniques. High-pressure processing and pulsed electric fields are emerging methods that target spore structures, offering alternatives to traditional heat treatment. In biotechnology, enzymes isolated from spore-forming thermophiles, such as amylases and proteases, are used in industrial processes due to their stability at elevated temperatures.
While spore heat resistance presents challenges in food safety, it also offers opportunities for innovation. By deciphering the molecular basis of this remarkable trait, we can develop strategies to control spore-forming pathogens and exploit their thermostable components for various applications. Further research into spore biology will undoubtedly lead to advancements in food security, biotechnology, and our understanding of life's adaptability to extreme environments.
Does Pseudomembranous Enterocolitis Produce Spores? Unraveling the Facts
You may want to see also

Spore vs. Thermophile Definition: Compares spore characteristics to the scientific definition of thermophiles
Spore-forming bacteria and thermophiles are often conflated due to their resilience, but their survival mechanisms differ fundamentally. Spores are dormant, highly resistant structures produced by certain bacteria, such as *Bacillus* and *Clostridium*, to endure harsh conditions like desiccation, radiation, and extreme temperatures. Thermophiles, in contrast, are organisms that thrive in high-temperature environments, typically between 50°C and 80°C, due to specialized enzymes and cell membranes adapted to heat stability. While some spore-forming bacteria can survive extreme heat, their spore form is not inherently thermophilic; it is a survival strategy, not a lifestyle.
To illustrate, consider *Geobacillus stearothermophilus*, a spore-forming bacterium often used as a bioindicator in sterilization processes. Its spores can withstand temperatures up to 121°C for 15 minutes, a trait exploited in autoclave validation. However, this bacterium is not a true thermophile because its vegetative form grows optimally at 60°C, not the extreme temperatures required for thermophilic classification. Thermophiles like *Thermus aquaticus*, on the other hand, actively grow at temperatures above 70°C, relying on heat-stable proteins rather than spore formation for survival.
From a practical standpoint, understanding this distinction is critical in industries like food safety and biotechnology. For instance, pasteurization at 72°C for 15 seconds targets vegetative bacteria but not spores, which require more aggressive methods like autoclaving. Thermophiles, however, are naturally resistant to pasteurization temperatures, necessitating specific control measures in dairy processing. Misidentifying spores as thermophiles could lead to inadequate sterilization protocols, while conflating thermophiles with spore-formers might overlook their unique enzymatic applications, such as *Taq* polymerase in PCR.
The key takeaway is that while spores and thermophiles both exhibit remarkable resilience, their mechanisms are distinct. Spores are a passive, protective state, whereas thermophiles actively metabolize in high-temperature environments. This distinction is not merely academic; it informs practical decisions in microbiology, from designing sterilization processes to harnessing extremophiles in biotechnology. Recognizing these differences ensures precision in both scientific inquiry and industrial application.
Discover Secret Tips to Score Free Food in Singapore Easily
You may want to see also

Environmental Spore Habitats: Investigates if spore habitats align with thermophilic temperature ranges
Spore-forming organisms, such as certain bacteria and fungi, are renowned for their resilience, capable of surviving extreme conditions. Thermophiles, on the other hand, are organisms that thrive in high-temperature environments, typically between 50°C and 80°C. The question arises: do spore habitats naturally align with these thermophilic temperature ranges? To investigate this, we must examine the environmental niches where spores are commonly found and compare them to known thermophilic zones.
Analyzing Spore Habitats:
Spores are often discovered in diverse environments, from soil and water to extreme locales like hot springs and deep-sea hydrothermal vents. For instance, *Bacillus* spores are prevalent in soil, where temperatures rarely exceed 40°C, while *Thermus aquaticus* spores inhabit hot springs with temperatures up to 70°C. This suggests that while some spore-forming organisms can survive thermophilic conditions, not all spore habitats fall within this temperature range. A critical factor is the distinction between spore *survival* and *optimal growth* temperatures, as spores may endure high heat without necessarily thriving in it.
Practical Investigation Steps:
To determine if spore habitats align with thermophilic ranges, follow these steps:
- Identify Target Organisms: Select spore-forming species from various environments (e.g., *Bacillus subtilis* from soil, *Thermus thermophilus* from hot springs).
- Measure Habitat Temperatures: Use thermocouples or data loggers to record temperatures in their natural habitats over time.
- Compare to Thermophilic Ranges: Overlay habitat temperatures against the 50°C–80°C thermophilic threshold.
- Laboratory Validation: Cultivate spores at different temperatures to confirm growth limits and compare with field data.
Cautions and Considerations:
While investigating, avoid assuming all spore-formers are thermophiles. For example, *Clostridium botulinum* spores survive in soil but are not thermophilic. Additionally, temperature is not the sole factor; pH, salinity, and oxygen levels also influence spore viability. Ensure measurements are accurate, as even small temperature variations can skew results. For instance, a 10°C difference can determine whether a spore germinates or remains dormant.
Takeaway and Implications:
Not all spore habitats align with thermophilic temperature ranges, but some spore-formers are indeed thermophiles. This distinction is crucial for applications like biotechnology, where thermostable enzymes (e.g., Taq polymerase from *Thermus aquaticus*) are derived from thermophilic spore-formers. Understanding these habitats helps predict spore behavior in extreme conditions, from food preservation to astrobiology. For practical use, always verify temperature tolerances of specific spore species before assuming thermophilic capabilities.
Are Pseudomonas Spore-Forming? Unraveling the Truth About This Bacterium
You may want to see also
Frequently asked questions
No, Spore is not a thermophile. Spore is a video game developed by Maxis and published by Electronic Arts, not a microorganism.
A thermophile is an organism that thrives in high-temperature environments, typically above 45°C. Spore, being a game, has no biological classification and is unrelated to thermophiles.
Spore does not specifically feature thermophiles. The game focuses on evolution and creature creation but does not include detailed classifications like thermophiles.
While players can create microorganisms in Spore, the game does not categorize or label them as thermophiles or any other specific biological type.
Spore does not have the capability to simulate specific environments like those inhabited by thermophiles. Its focus is on general evolution and creativity rather than scientific accuracy.

